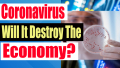

James L. Paris's Blog, page 22
March 23, 2020
Bitcoin And Cryptocurrency Movement In The U.S. Northern Mariana Islands
Jim welcomes to the broadcast Alex Ugorji, founder of Crypto Frontier. Crypto Frontier is a movement to bring cryptocurrency focused businesses to the U.S. Northern Mariana Islands. On this episode Alex shares the remarkably low cost of living in the Mariana Islands, what it is like to live there, and the unique tax arrangement as a territory of the United States. He also shares his vision for creating a cluster of cryptocurrency focused businesses and entrepreneurs in the largest of the islands, Saipan.
Coronavirus: Is The Government's Response Worse Than The Virus Itself?
Jim shares the hard numbers of the Coronavirus and says that the government response has gone beyond overboard. Closing down the entire U.S. economy makes no sense based on the number of deaths. To make matters worse, states like Florida that have minimal cases are being pressured to follow what is being done in states that are hotbeds for Coronavirus. Jim breaks down the numbers and shares his view that the government response is worse than Coronavirus itself.
March 16, 2020
Medical Doctor Shares What To Do Now To Protect Yourself From Coronavirus
Dr. Elaina George joins Jim Paris Live to discuss what you can do now about the Coronavirus. What steps you can take to stay safe and reduce the odds that you will contract it, what supplements will boost your immune system, which is better hand washing or hand sanitizer?, will warm weather shorten the spread of Coronavirus?, how many weeks or months could this last?, why young people should still be concerned about exposure, and what to do if you begin to have Coronavirus symptoms.
Is Rush Limbaugh Fueling The Coronavirus Deniers Movement?
On this episode - Governors of Illinois and Ohio order the closing of all restaurants and bars, food is running out due to panic buying, is Rush Limbaugh fueling conspiracy theories about Coronavirus?, what will happen next for stocks and cryptocurrency, why banks are not lowering mortgage rates any further, and are we about to see all out martial law?
March 9, 2020
How A 27 Year Old Retired On $10,000 A Month In Passive Income (Rachel Richards)
Finance guru, former financial advisor, and Amazon bestselling author of Money Honey, Rachel Richards has one goal in mind: teaching you everything you need to know to become financially free earlier than you ever thought possible. At age 27, Rachel quit her job and retired, living off $10,000+ per month in passive income streams. Let her show you how to do it at any age���it's never too late. What is passive income? Passive income is earned with little to no ongoing work. It's no get-rich-quick scheme, but once your passive income exceeds your expenses, you are set for life.
In a refreshingly realistic how-to guide, Rachel serves up 28 tried and true passive income stream models, helping you to: Achieve "Financial Independence, Retire Early" without penny-pinching Create consistent, long-term residual income (the non-multi-level-marketing way), so you can live life on your terms
Have the flexibility to work when, where, and if you want
Say "goodbye" to your 9-5, and create a life you totally love
Eliminate your money stresses and fears
NY AG Orders Televangelist Jim Bakker To Stop Promoting Coronavirus 'Cure'
On this episode - New York Attorney General orders TV evangelist Jim Bakker to stop promoting a nutritional supplement as a 'cure' for Coronavirus. U.S. State Department warns people not to go on cruises, did the White House overrule its own experts that wanted to warn senior citizens not to fly?, financial markets continue to be spooked as 10 year treasury hits record low and Wall Street braces for down open on Monday, Hunter Biden facing contempt of court charges this week, and the story of an Illinois woman that could lose her home due to skyrocketing property taxes.
March 3, 2020
Coronavirus: Interest Rates Collapse - How To Cash In Before They Go Back Up
Coronavirus has pushed mortgage rates to an 8 year low. A short video here on how to take advantage of these low interest rates on mortgages, car loans, consumer loans, and student loans. Now is the time to act to cut your borrowing costs and take advantage of these historically low rates before they go back up.
March 2, 2020
The Death Of Princess Diana: Was It A Conspiracy Or Just A Tragic Accident?
���This particular phase in my life is the most dangerous. My husband is planning ���an accident��� in my car, brake failure and serious head injury in order to make the path clear for him to marry.��� ���Letter written by Princess Diana, late 1996 It is a moment that remains frozen in history. When the Mercedes carrying Diana, Princess of Wales, spun fatally out of control in the Pont de l���Alma tunnel in Paris in August 1997, the world was shocked by what appeared to be a terrible accident. But two decades later, the circumstances surrounding what really happened that night���and, crucially, why it happened���remain mired in suspicion, controversy, and misinformation. Until now.
Dylan Howard has re-examined all of the evidence surrounding Diana���s death���official documents, eyewitness testimony and Diana���s own private journals���as well as amassing dozens of new interviews with investigators, witnesses, and those closest to the princess to ask one very simple question: Was the death of Princess Diana a tragedy���or treason? Diana: Case Solved has uncovered in unprecedented detail just how much of a threat Diana became to the establishment. In these pages you will learn of the covert diaries and recordings she made, logging the Windsors��� most intimate secrets and hidden scandals as a desperate kind of insurance policy. You will learn how the royals were not the only powerful enemies she made, as her ground-breaking campaigns against AIDS and landmines drew admiration from the public, but also enmity from powerful establishment figures including international arms dealers, the British and American governments, and the MI6 and the CIA.
Coronavirus: The Economy Is Going To Take A Hit No Matter What
On this episode - Biden wins in SC, Mayor Pete drops out, the strange Shincheonji cult behind the explosion of Coronavirus cases in South Korea, and why the economy is going to take a hit no matter what happens with the Coronavirus.
February 24, 2020
Bible Prophecy Expert Discusses The Coronavirus, Locusts, And World Events
Bible prophecy expert LA Marzulli joins Jim Paris Live. On this episode - the Coronavirus and Bible prophecy. Are locusts and earthquakes warnings and precursors to the second coming of Christ? How do we interpret modern day events within the context of Bible prophecy? Why are so many Christians and churches ignoring these signs of the end of days?